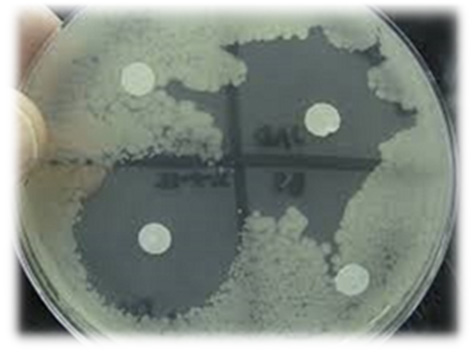
유인균

휴먼마이크로바이옴(Human microbiome)으로서 유익하게 인체에 작용하는 미생물을 광범위하게 포함하는 균을 뜻합니다.
즉 유인균이란 유효성 인체 균을 뜻합니다.
01유익균? 유인균?
- 유익균
- 유해균의 반대되는 말로 사람몸에 유해함을 주지않는 모든 균류를 총칭
- 유인균
- 자연환경내에 유익균이 우점하도록 유인(attract)하는 강한능력을 가진 균주만을 가리키며, 중간균을 유익균으로 유도하는 역할 수행.
02유산균, 프로바이오틱스 그리고 유인균의 관계


-
유인균
프로바이오틱스 + 효모 / 정부 연구지원금으로 개발된 유인균
-
프로바이오틱스
유산균 + 일부 Bacillus
-
유산균
Lactobacillus, Lactococcus, Leuconostoc, Pediococcus, Bifidobacterium 등의 균속
대장균이 배양된 플레이트에 특허 유인균을 접종하고 일정시간 배양 후 모습입니다.
유인균을 중심으로 투명한 환이 생성되었습니다. 이는 대장균이 자라지 못해 생긴 것입니다.
유인균이 생장하면서 항균 작용을 하는 대사물질을 생산합니다.
항균물질에 의해 균의 생장이 저해되는 것을 항균작용이라고 하는데, 이 작용이 대장균에게 발생하게 됩니다.
유인균은 자신이 만들어내는 항균물질을 이용하여 생장환경 내에서 우점을 차지하게 됩니다.
한국의과학연구원은 유인균의 이러한 특성을 이용하고자 하였으며, 다음과 같은 컨셉으로 특허 유인균을 연구개발하였습니다.
- 첫째, 동일한 레시피를 사용하면 동일한 맛이 난다.
- 둘째, 어느 지역에서 만들어도 동일한 맛이 난다.
- 셋째, 최종적으로는 특허 유인균이 우점종으로 나타난다.
- 유인균
-
- 유익한 균이 우점되도록 유인하는 균
- 유익하게 인체에 작용하는 균
03유인균이 포함하고 있는 미생물
고초균

Bacillus subtilis BSS09, Bacillus subtilis BSS11
- Bacillus subtilis BSS09 : 김치에서 분리된 고초균
- Bacillus subtilis BSS11 : 낫토에서 분리된 낫토균
- 식품의 발효에 이용되는 유익한 균
- 발효과정 중에 생성되는 발암물질인 아프라톡신의 생성을 억제
- 소화촉진과 정장효과에 우수한 효능을 보임
효모균

Saccharomyces cerevisiae BSS01
- 고추장에서 분리된 효모
- 빵·맥주 등을 만드는 빵효모로 알려짐
- 된장의 풍미에 관여하고 알코올발효를 함
- 단백질이 50% 이상이며, 비타민 B과 B, 니아신, 엽산(폴산)의 풍부한 공급원
- 양조효모는 비타민 보충제로서 복용
- 풍부한 각종 영양소 함유 : 비타민, 소화효소, 미네랄, 미지성장인자(UGF)함유
- 기호성 증진 : Nucleotidies, glutamic acid의 방출
- 대사물질 방출 : pH6.5에서 주로 소화효소를 동원하여 세포벽을 분해하여 내용물을 소화관에 방출
유산균
유산균의 특징
: 다량의 젖산을 생성하면서 식품이나, 동물의 장과 같은 숙주 내에 해로운 물질인 Indole, skatole, phenol, amine 및 암모니아 등을 생성하지 않고 부패를 방지하는 등의 유익한 작용을 하는 세균
유산균의 알려진 효능성분
-
01
발효 기질로 되는 성분(단백질, 지방질, 탄수화물, 비타민무기질)
-
02
함유되는 유산균의 세포벽 성분, 세포질 성분, 효소 등의 균체 성분
-
03
유기산 이외에 유산균으로 생산되는 다당류, 항균성 물질
-
04
소화 내에 있어서 살아있는 유산균 및 유산균의 기능
※ 이러한 효능성분을 갖춘 유산균은 숙주에 정장작용,면역력 증가,간기능 개선 및 영양 가치 증진 등 다양한 영향을 줌

Lactobacillus brevis BSS04
- 김치에서 분리
- 김치의 발효 후기에 많이 나타남
- 면역력 증진
- 헬리코박터균을 억제하여 위염증 감소시킴
- 잇몸 및 구강궤양에 효과적임
- 항염 작용이 뛰어남
- 덱스트란을 만들어내는 대표적인 유산균

Lactobacillus casei BSS05
- 청국장에서 분리
- 전통발효유 및 치즈발효에 많이 이용됨
- 유해균 억제
- 면역조절기능 강화
- 설사 감소에 도움
- 변비를 개선하는 데에도 효과가 있음
- 피부개선작용이 있어서 화장품 소재로서의 유용성이 있음
- 항암 및 항알러지 효과가 있는 것으로 연구됨

Lactobacillus plantarum HS729
- 렌틸콩에서 분리
- 항균물질을 생산
- 락툴린을 생산하여 포진바이러스를 억제
- 면역 기능 조절
- 독소 제거 능력이 뛰어남
- 우리나라 김치의 발효 후기에 중요한 역할을 함
- 설사를 일으키는 클로스트리듐 디피실리균이나 질염을 일으키는 칸디다균, 화농성 질환을 일으키는 포도상구균, 대장균을 죽이는 능력

Lactobacillus sakei MG521
- 김치에서 분리
- 생선육이나 육고기의 발효에 이용
- 사케나 막걸리 제조용의 유익균으로 이용
- 면역반응을 자극
- 병원성 세균의 증식을 억제
- 국내에서 아토피 치료 효능을 가진 미생물로 발견
- 면역과민반응에 의한 피부상태 개선에 도움

Lactobacillus salivarius SW709
- 청국장에서 분리
- 유산균증식 및 유해균억제에 도움을 줌
- 배변활동 원활에 도움을 줌
- 소화 및 정장작용에 도움을 줌

Leuconostoc citreum BSS07
- 된장에서 분리
- 장출혈성 대장균 O-157의 생장 억제
- 김치발효의 초기와 중기에 많은 역할
- 김치발효에서 다른 유산균의 생장을 억제
- 김치발효의 종균으로 이용 가능
- 다이어트, 면역력 향상, 변비 개선 등에도 도움
- 프로바이오틱스에는 포함되지 않음

Leuconostoc mesenteroides SY1118
- 신생아의 장에서 분리
- 김치발효 초기에 우점을 차지
- 김치가 맛있다고 느껴질 때까지 발효를 주도함
- 덱스트란(dextran)이라는 식이섬유를 만들어 변비에 도움을 줌
- 김치 초기 발효시에 젖산과 탄산을 만들어 상큼하고 개운한 맛을 내줌
- 김치, 독일식 김치(sauerkraut), 야채발효, 제빵발효에 이용가능

Streptococcus thermophilus BSS08
- 된장에서 분리
- 유산생산능력이 뛰어남
- 치즈나 요쿠르트 제조에 사용
- 유당분해효과가 뛰어남
- 항암 작용에도 효능이 있음
- 구강 충치균에 저해능을 보이기도 함
- 면역력 증진

Weissella koreensis BSS10
- 김치에서 분리
- 오르니틴을 생성하는 기능
- 지방세포의 중성지방 생성을 억제
건강기능식품용 유인균

Enterococcus faecalis BSS03
- 청국장에서 분리
- 인간의 체내에 원래부터 존재하는 유산균
- 높은 단백질 분해율
- 장내정착성이 강함
- 유해균 억제능력 및 중금속 제거 탁월

- Effects of bacteriocin produced by E. faecalis MJ-213 alone or in combination with potassium sorbate against S. aureus ATCC 6538

Enterococcus faecium BSS02
- 렌틸콩에서 분리
- 인간의 체내에 원래부터 존재하는 유산균
- 건강기능식품으로 사용 가능한 장내구균으로 Enterococcus faecalis, Enterococcus faecium 두 종만 섭취가능
- 카드늄과 같은 중금속 제거에 효과를 보임
유인균의 활용 :발효스타터, 천연발효식초 제조등 발효 전반

발효전문가자격 관리

우리는 한국인의 건강과 취향에 맞는 우리의 균 유인균이 올바른 식문화, 발효문화를 이끌어갈 것을 믿습니다.

![]() 유산균
유산균![]() 프로바이오틱스
프로바이오틱스![]() 유인균
유인균